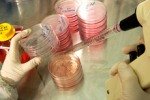
Ученые придумали, как можно быстро выращивать стволовые клетки

Тег: Придумали

Ставропольские ЮИДовцы придумали новый дорожный знак
В Ставропольском крае сотрудники Госавтоинспекции и юные инспектора движения Кировского района в преддверии майских праздников, когда многие семьи отп...

Гуф и его жена придумали развод
До сего момента не успокоились разговоры по поводу развода звездного семейства рэпера Гуфа и его супруги Айзы Долматовой. Изначально появилась версия,...

Американские студенты придумали, как снизить зависимость от Facebook
Студенты из Массачусетского технологического института (США) придумали, как избавить от зависимости тех, кто слишком часто выходит с социальную сеть...

Ставропольские судебные приставы придумали новый способ борьбы с должниками по коммуналке
Для УФССП России по Ставропольскому краю взыскание долгов по ЖКХ – одно из важных направлений деятельности. Ведь проблема неуплаты коммунальных услуг...

Рудковская и Плющенко придумали имя ребенку
Благовидная пара российского шоу-бизнеса Яна Рудковская и Евгений Плющенко на данный момент с великим трепетом ждут пополнения в семействе...
Ученые придумали, как можно быстро выращивать стволовые клетки
Поверхность, которая позволяет справиться с проблемами, связанными с выращиванием взрослых стволовых клеток, была разработана группой экспертов...

В ЮАР придумали презерватив против изнасилования
Врач Соннет Эглерс, пообщавшись с одной из жертв изнасилования, озадачилась идей придумать устройство, которое хоть как-то защитит слабую женщину от н...

На Украине придумали... Музыкальный презерватив
Григорий Чаусовский, ученый Украины, сделал прорыв в сексиндустрии и изобрел музыкальный презерватив, как утверждает создатель изобретения, он может н...